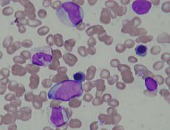
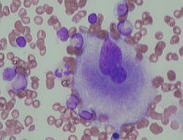

血液検査
血液検査とは・・
貧血や白血病などの血液疾患や血液凝固異常を診断する時に欠かせない検査の1つです。主な検査には血球数算定検査、末梢血液像、凝固検査、骨髄像があります。
血球数算定検査(血算)
血球数算定検査とは各血球の数(白血球数・赤血球数・血小板数)、ヘモグロビン、ヘマトクリットなどを多項目自動分析装置を用いて測定する検査です。 血液疾患の診断や治療効果を見るときなどの基本的なデータになります。
| 検査には全血を用います。 検査用の血液は、血液を固まらないようにする薬品(EDTA-2K)の入った容器に採血します。これをよく混ぜて分析装置にかけます。 |
![]() |
| 血算用採血管 |
末梢血液像
| 末梢血液像とは、血液をガラス板に薄く引いて、血中の細胞が見やすいように染色し、顕微鏡で観察する検査のことです。 | ![]() |
| 末梢血標本 |
主に赤血球・白血球・血小板の形の変化や異常細胞の有無を観察しています。白血球は顆粒球(好中球・好酸球・好塩基球)、単球、リンパ球に分類します。 血算と血液像を併用して行うことで、貧血や白血病を含む各種血液疾患の診断に役立つ情報を得ることができます。
![]() |
![]() |
![]() |
| 好中球 | リンパ球 | 単球 |
![]() |
![]() |
![]() |
| 好酸球 | 好塩基球 |
凝固検査
凝固検査はDIC(播種性血管内凝固症候群)・肝障害・血友病などの凝固異常のある方や血液を固まりにくくするお薬を飲まれている方の薬剤効果を見るのにも役立ちます。またこの検査は手術前の必須検査となっています。
![]()
検査には血漿を用います。検査用の血液は、血液を固まらないようにする薬品(クエン酸ナトリウム)の入った容器に採血します。これを遠心分離すると血漿と血球に分けることができます。 血液というのは約半分が血漿と呼ばれる栄養素を含んだ液体で、血液の中には白血球・赤血球・血小板などの成分が浮かんでいます。血液が固まるには血小板が大切な役割りをしていますが、それ以外にも血液を固まらせる物質が関係しています。
この血漿には血液を固まらせる物質=凝固因子を含んでいて、凝固因子が働くことで血管の傷に硬いふたを作っています。《止血作用》
凝固検査は血液を固まらせる物質=凝固因子がしっかり働いているかを見るための検査です。
|
遠心 |
||
| 遠心前 | 遠心後 |
骨髄像
骨髄検査を行うことで血液を作っている状態や血球の成熟度、異常細胞の有無などを見ることができ、貧血や白血病を含む各種血液疾患の診断に役立つ情報を得ることができます。
骨髄とは血液を作り出す重要な部分で、骨の中心にあります。骨髄で作られる血液を骨髄血といいます。骨髄で作られた血液は全身へ送られます。
医師が骨髄穿刺を行ない、採取した骨髄液を用います。骨髄液は固まりやすいため、検査技師がベットサイドで骨髄液をガラス板に引きます。その後で細胞が見やすいように染色し、顕微鏡で観察します。
![]() |
![]() |
![]() |
| 採取された骨髄血 | 骨髄標本 | 鏡検時風景 |
![]() |
![]() |
| 正常骨髄液中に認める細胞 | |
また染色の種類を変えることによって特に白血病の診断に重要な情報を得ることができます。
![]() |
![]() |
![]() |
| ペルオキシダーゼ染色 | エステラーゼ二重染色 | 鉄染色 |